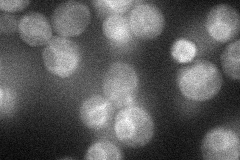
YHR142W
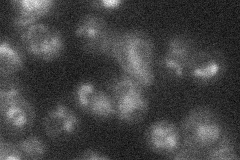
YHR142W
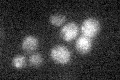
YHR142W

View description
Protein of unknown function, involved in chitin biosynthesis by regulating Chs3p export from the ER
Localization:
Intensity:
Fold change:
Significance:
-
C’ GFP library in SD

punctate29.91 -
N' NOP1pr-GFP in SD
ER27.9878 -
N' TEF2pr-mCherry in SD
vacuole15.1873 -
N' NATIVEpr-GFP in SD

ambiguous,cytosol23.2395 -
N' TEF2pr-VC and Cyto-VN in SD

below threshold22.8904 -
C’ GFP library in SD+DTT

punctate32.11.07No -
C’ GFP library in SD+H2O2

punctate19.710.65Yes -
C’ GFP library in Starvation Media
punctate22.550.75No -
C’ GFP library on the background of Pup2-DaMP

punctate -
C’ GFP library on the background of CCT mutant

punctate24.22780.809833No
